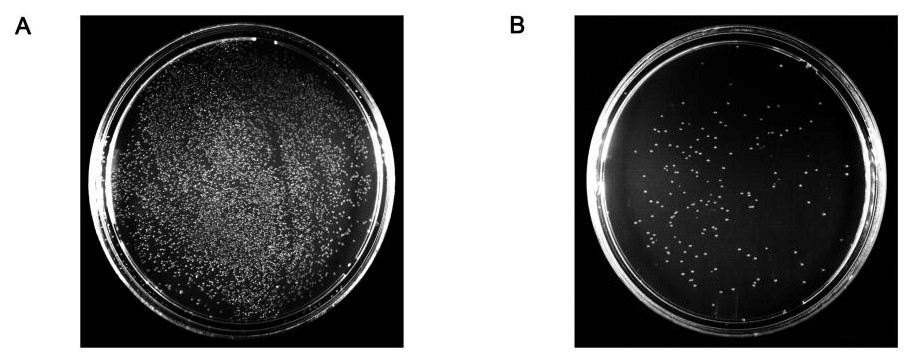

新品上架:去磷酸化工具酶专场—活性高,使用方便
近年来随着蛋白质组技术的不断发展,蛋白质磷酸化的研究受到越来越广泛的关注。 某个蛋白位点的磷酸化是否影响其活性? 是否引起蛋白结构的变化? 是否影响蛋白间的相互作用? 实验中的你是否需要解决上述问题?碧云天全新推出Lambda Protein Phosphatase,能够去除多种氨基酸残基的磷酸化,是研究蛋白磷酸化与其活性和结构的必备武器!同时还可以验证蛋白磷酸化位点抗体的特异性哦。 碧云天生产的Lambda Protein Phosphatase (重组λ蛋白磷酸酶),即λ Protein Phosphatase,是一种锰离子(Mn2+)依赖的重组表达纯化的磷酸蛋白酶,可以对磷酸化的丝氨酸、苏氨酸、酪氨酸和组氨酸残基进行脱磷酸化反应。本产品是大肠杆菌重组表达的带6×His标签的重组λ磷酸酶。该磷酸酶由λ噬菌体开放阅读框ORF221所编码,编码产物共包含221个氨基酸残基。Lambda Protein Phosphatase可以用于蛋白的去磷酸化,从而可以用于研究蛋白磷酸化与其活性和结构的关系,以及验证蛋白磷酸化位点抗体的特异性等。

图1. Lambda Protein Phosphatase酶活测定实验图。左图:pNP标准曲线。右图:Lambda Protein Phosphatase按照30、40、50、80、100、200、500倍稀释后,在50µl反应体系中的酶量分别为0.27µg、0.20µg、0.16µg、0.10µg、0.08µg、0.04µg、0.016µg,并与100mM pNPP在1×Lambda Protein Phosphatase Buffer和1×MnCl2中在30℃反应5min后,加入12.5µl 3M NaOH终止反应,测定产生的pNP在405nm吸光度,并根据pNP标准曲线,计算Lambda Protein Phosphatase酶活性。不同批次检测出来的酶活性会略有差别。
| 产品编号 | 产品名称 | 产品包装 | 产品价格 |
| P2316S | Lambda Protein Phosphatase | 20kU | 256.00元 |
| P2316M | Lambda Protein Phosphatase | 100kU | 972.00元 |
说完蛋白磷酸化,咱们再来看看核酸磷酸化。 做克隆转化长了满板子,PCR鉴定都不对…… 经常做克隆的小伙伴们太感同身受了有木有??? 看着长了不少单菌落,PCR验证全是假阳性!!! 别担心,试试看碧云天全新推出的假阳性终结者—Antarctic Phosphatase (Thermosensitive),有效避免载体自连,大大提高基因克隆阳性率! 碧云天生产的Antarctic Phosphatase (Thermosensitive),是一种源自南极微生物的、热敏感的重组表达纯化的磷酸酶,可以催化去除DNA、RNA、dNTP、rNTP 5'或3'末端磷酸基团。DNA或RNA 5'端脱去磷酸基团(简称脱磷或去磷)后就不能被连接酶(ligase)所连接,常用于避免载体的自连、提高基因克隆时的阳性率、选择性连接特定序列等。
快速去磷酸化: 只需37℃孵育15分钟即可; 快速失活: 75℃孵育5分钟即可完全失活; 活性高,使用方便:在各种内切酶和PCR缓冲液中保持不低于100%的活性,可以和质粒DNA的酶切等同时进行; 兼容性强:对于5'或3'突出末端、平端等各种DNA的脱磷酸化采用完全相同的操作步骤; 适用于后续的连接反应:经Antarctic Phosphatase脱磷酸基团,并75℃孵育5分钟失活后,通过柱纯化或凝胶电泳后切胶回收纯化等适当处理后,即可用于后续的连接反应。
1.通过去除载体或DNA片段5'末端的磷酸基团,防止载体或DNA片段自连; 2.质粒DNA同时进行内切酶消化和脱磷; 3.通过5'末端脱磷,制备用于T4PNK进行5'末端标记的DNA或RNA; 4.去除DNA、RNA、rNTP和dNTP的5'末端的磷酸基团; 5.PCR产物中去除dNTP和焦磷酸根; 6.也可用于蛋白质丝氨酸、苏氨酸、酪氨酸残基的去磷酸化。
图2. 碧云天生产的Antarctic Phosphatase对BamHI单酶切后的pUC18载体进行脱磷处理可以大大降低载体自连。

图3. 碧云天生产的Antarctic Phosphatase对EcoRI/BamHI双酶切后的pUC18载体进行脱磷处理可以大大提高克隆的阳性率。
| 产品编号 | 产品名称 | 产品包装 | 产品价格 |
| D7028S | Antarctic Phosphatase (Thermosensitive) | 1000U | 208.00元 |
| D7028M | Antarctic Phosphatase (Thermosensitive) | 5000U | 828.00元 |
